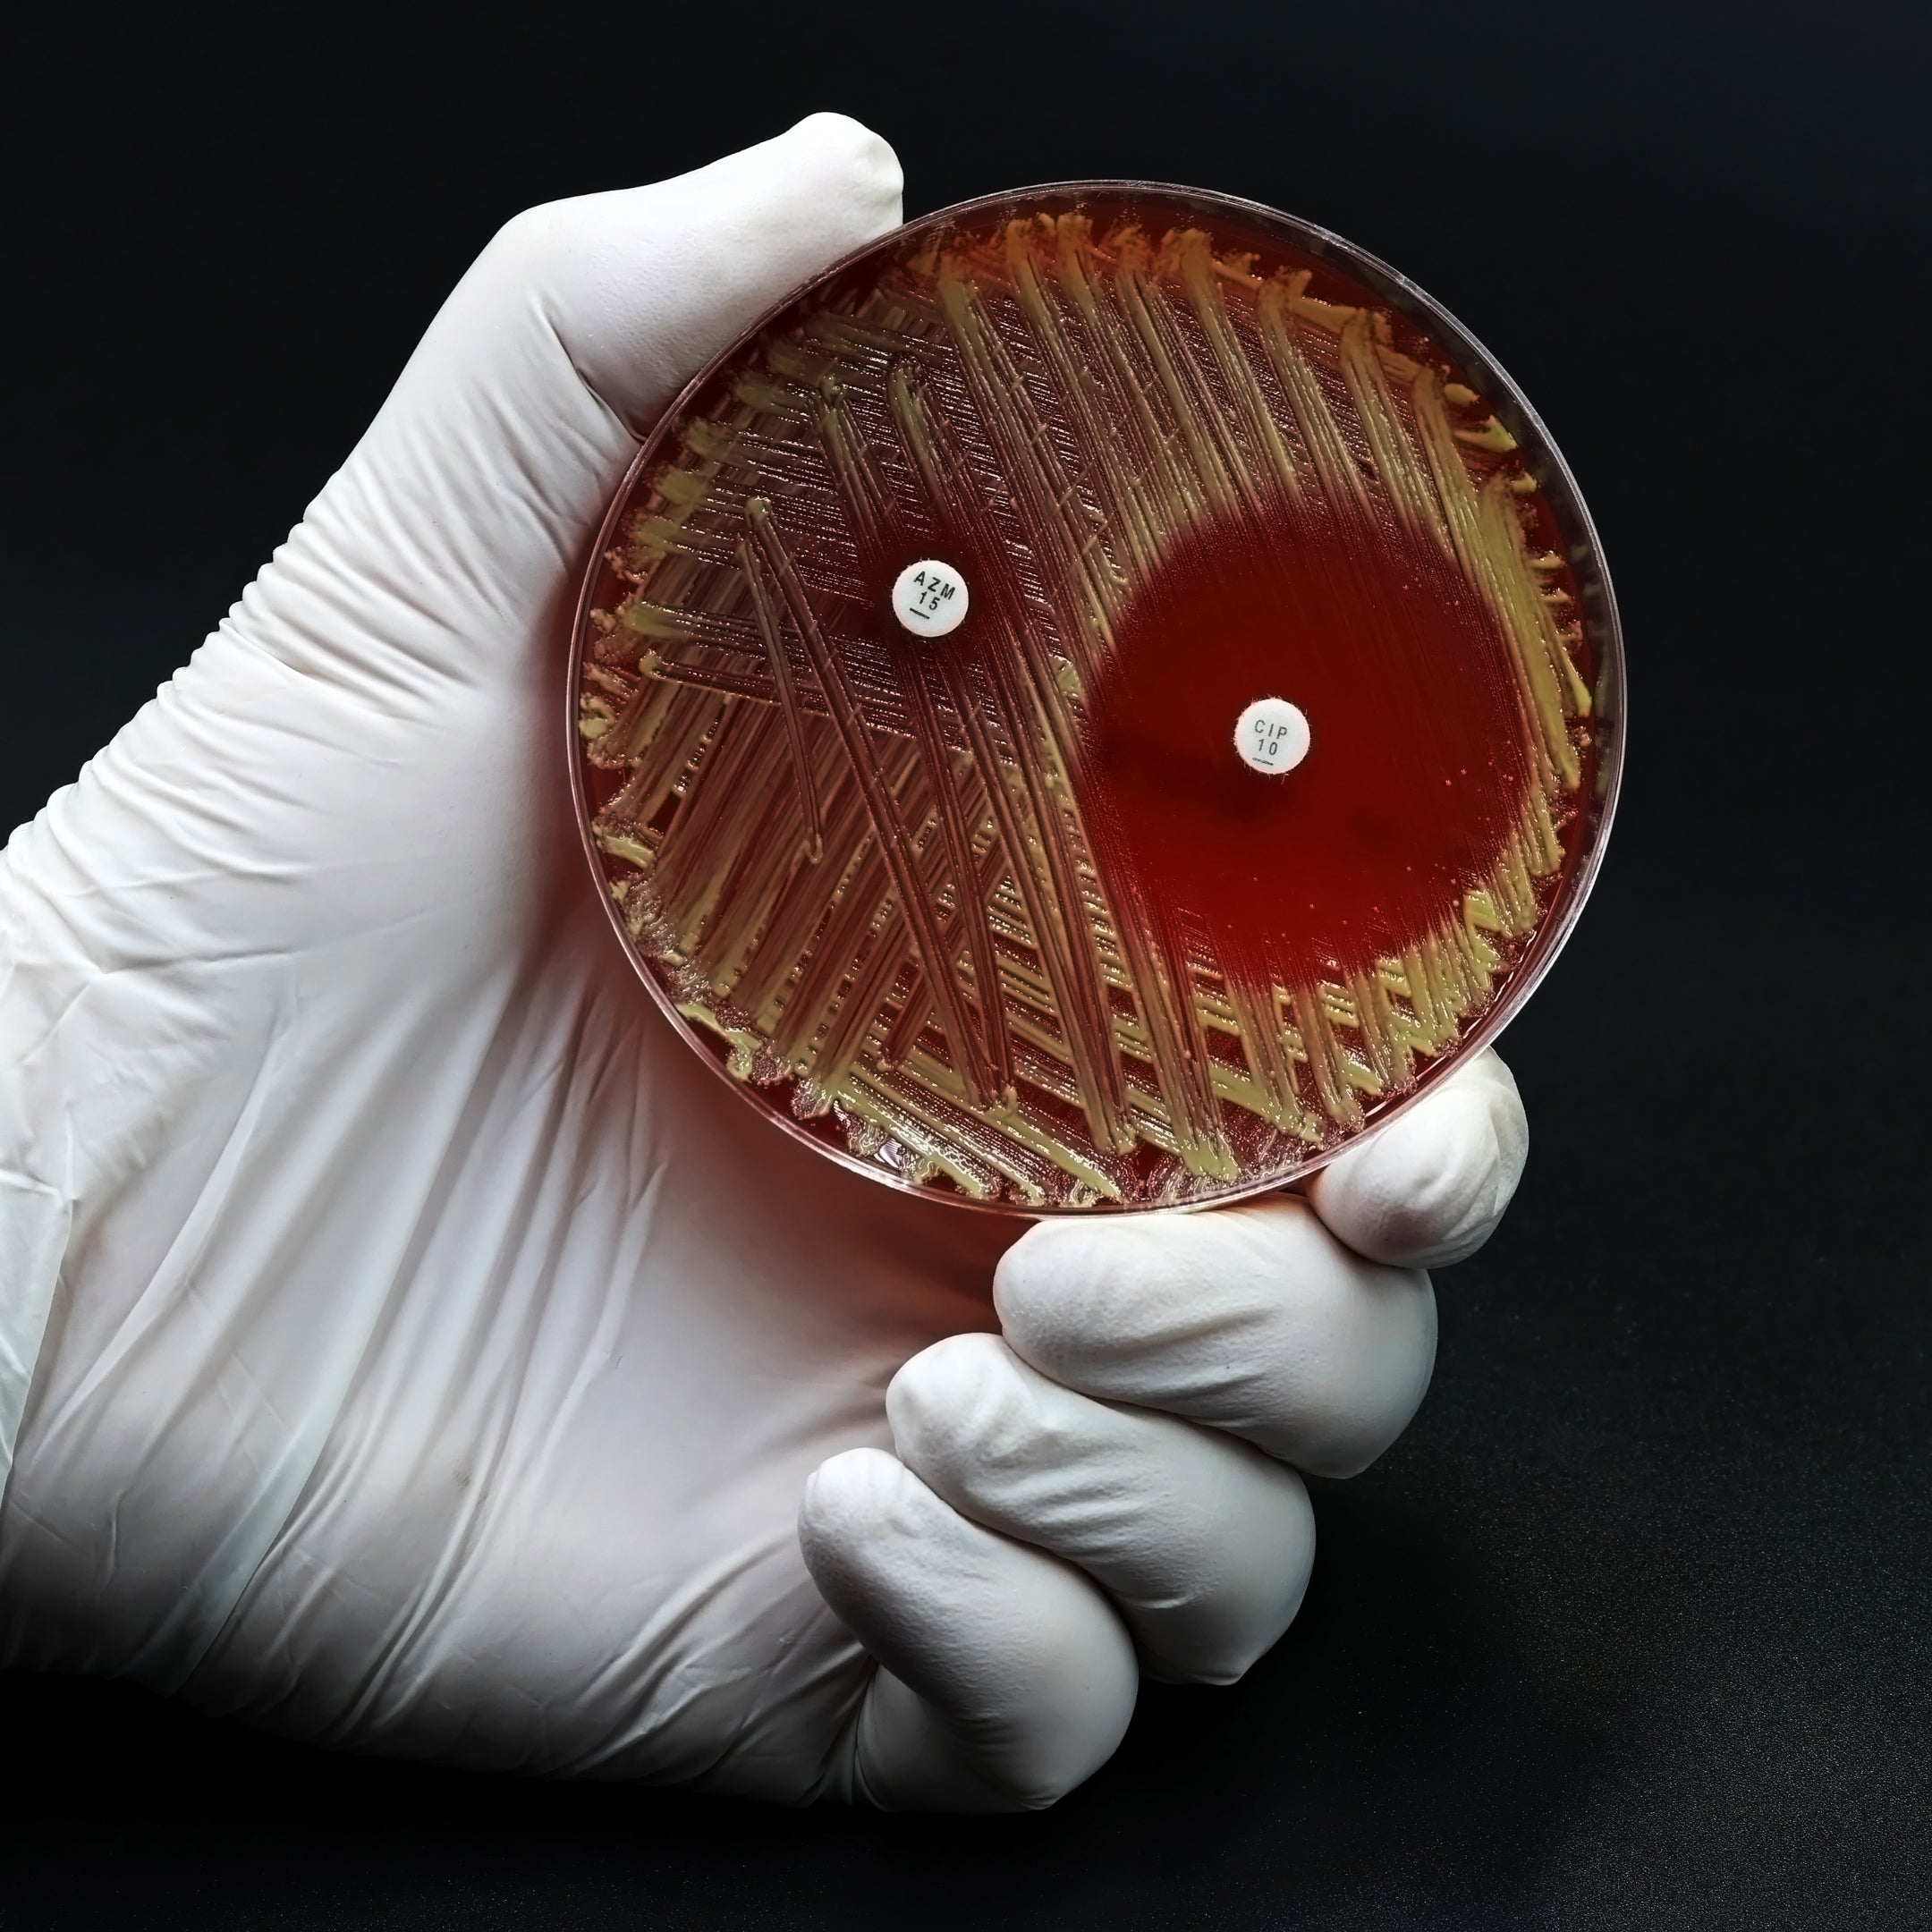

The Healing Power of Manuka Honey for Horse Wounds and Cuts
When it comes to equine care, providing the best solutions for wound healing is vital. At Bioactive Honey Co, we understand the importance of innovative, natural products to support your horse's health. Harnessing the power of Manuka Honey, our bioactive honey is a trusted ally in promoting faster recovery and ensuring optimal care for horse wounds and cuts.

Why Choose Manuka Honey for Equine Wound Care?
Manuka Honey, especially with high MGO (Methylglyoxal) levels, is renowned for its antibacterial, anti-inflammatory, and healing properties. Backed by research and trusted by veterinarians worldwide, it’s an exceptional natural remedy for managing equine wounds, minimizing infections, and enhancing the healing process.
1. Unmatched Antibacterial Properties
Manuka Honey’s potent antibacterial activity helps protect wounds from harmful pathogens such as Staphylococcus aureus and Pseudomonas aeruginosa that often cause infections in horses. This unique bioactivity is attributed to the high levels of MGO and other bioactive compounds. (Source: TheHorse.com)

2. Accelerates Healing
Clinical studies show that applying Manuka Honey to wounds can speed up tissue regeneration and reduce scarring. It also maintains a moist wound environment, which is ideal for new cell growth. (Source: PubMed)

3. Reduces Inflammation and Pain
Manuka Honey’s natural anti-inflammatory effects alleviate swelling and discomfort, making it an ideal choice for horses recovering from injuries or surgeries. (Source: Sydney.edu.au)

4. Protects Against Debris and Contaminants
When applied, Manuka Honey creates a natural barrier over the wound, shielding it from dirt and contaminants while aiding in debridement—the gentle removal of dead or damaged tissue.
How to Use Manuka Honey for Horse Wounds
• Clean the Wound: Gently clean the area with sterile water or saline solution to remove debris.
• Apply Manuka Honey: Spread a thin layer of high-grade MGO Manuka Honey directly onto the wound or a dressing.
• Cover with a Bandage: Protect the treated area with a non-stick dressing and secure it with vet wrap.
• Repeat Daily: Replace the dressing and reapply the honey daily to ensure optimal healing.

Why Bioactive Honey Co?
At Bioactive Honey Co, our Manuka Honey is sourced from the pristine landscapes of New South Wales, Australia, ensuring the highest standards of purity and quality. Every jar is independently tested for MGO and TA levels to guarantee the bioactivity your horse needs for effective wound care.
Key Benefits of Our Honey for Horses:
-
100% Pure, Australian-Sourced
From hive to jar, we ensure no blending or imported materials.
-
Proven Efficacy
Independently verified by accredited labs for MGO and bioactive compounds.
-
Trusted by Professionals
Used across veterinary, fitness, and medicinal industries.

Real Results You Can Trust
Horses treated with Manuka Honey have shown remarkable healing improvements within days. From small cuts to larger abrasions, our honey has been a go-to remedy for horse owners seeking reliable, natural wound care solutions.

References
• TheHorse.com: Evidence Supporting Manuka Honey for Horse Wounds
• PubMed: Manuka Honey’s Role in Wound Healing
• Sydney.edu.au: High UMF Honey for Contaminated Horse Wounds